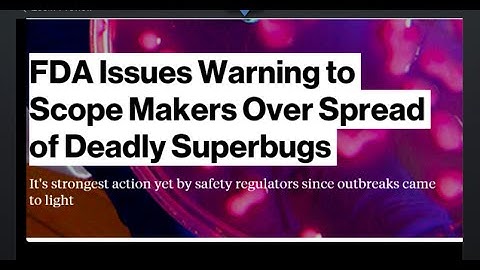
FDA Warns Co. over Superbugs in Endoscopes!

⬇ DOWNLOAD NOW
Kalau muncul iklan pop-up, tutup lalu klik tombol kembali
Download lagu FDA attributes spread of superbug to endoscope secara gratis hanya untuk keperluan promosi. Dukung artis favorit kamu dengan membeli musik original di iTunes atau platform resmi lainnya.
 Watch Out for Endoscopes Linked to Superbug Outbreak, FDA Says
Watch Out for Endoscopes Linked to Superbug Outbreak, FDA Says
 Deadly superbug scare: FDA warns doctors to properly sterilize devices
Deadly superbug scare: FDA warns doctors to properly sterilize devices
 'Superbug' Outbreak Prompts FDA To Step In
'Superbug' Outbreak Prompts FDA To Step In
 FILE-SUPERBUG-HOW LONG DID FDA KNOW?
FILE-SUPERBUG-HOW LONG DID FDA KNOW?
FDA Warns Co. over Superbugs in Endoscopes!
FDA Warns Co. over Superbugs in Endoscopes!
 FDA Warns Manufacturers Linked to Superbugs
FDA Warns Manufacturers Linked to Superbugs
 Slowing the Spread of Superbugs
Slowing the Spread of Superbugs
 Superbug Spread Prompts CDC Concern
Superbug Spread Prompts CDC Concern